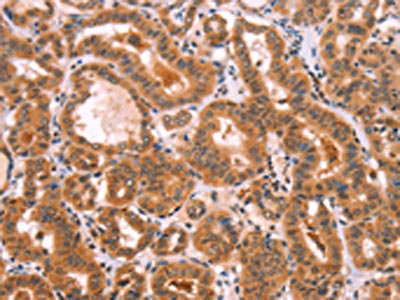

NCEH1 Antibody
-
中文名稱:NCEH1兔多克隆抗體
-
貨號:CSB-PA063661
-
規格:¥1100
-
圖片:
-
The image on the left is immunohistochemistry of paraffin-embedded Human thyroid cancer tissue using CSB-PA063661(NCEH1 Antibody) at dilution 1/80, on the right is treated with fusion protein. (Original magnification: ×200)
-
The image on the left is immunohistochemistry of paraffin-embedded Human brain tissue using CSB-PA063661(NCEH1 Antibody) at dilution 1/80, on the right is treated with fusion protein. (Original magnification: ×200)
-
Gel: 10%SDS-PAGE, Lysate: 40 μg, Lane 1-2: Mouse kidney tissue, Mouse heart tissue, Primary antibody: CSB-PA063661(NCEH1 Antibody) at dilution 1/1350, Secondary antibody: Goat anti rabbit IgG at 1/8000 dilution, Exposure time: 30 seconds
-
-
其他:
產品詳情
-
Uniprot No.:
-
基因名:
-
別名:Arylacetamide deacetylase like 1 antibody; Arylacetamide deacetylase-like 1 antibody; NCEH antibody; Nceh1 antibody; NCEH1_HUMAN antibody; Neutral cholesterol ester hydrolase 1 antibody; Neutral cholesterol ester hydrolase antibody
-
宿主:Rabbit
-
反應種屬:Human,Mouse,Rat
-
免疫原:Fusion protein of Human NCEH1
-
免疫原種屬:Homo sapiens (Human)
-
標記方式:Non-conjugated
-
抗體亞型:IgG
-
純化方式:Antigen affinity purification
-
濃度:It differs from different batches. Please contact us to confirm it.
-
保存緩沖液:-20°C, pH7.4 PBS, 0.05% NaN3, 40% Glycerol
-
產品提供形式:Liquid
-
應用范圍:ELISA,WB,IHC
-
推薦稀釋比:
Application Recommended Dilution ELISA 1:2000-1:10000 WB 1:1000-1:5000 IHC 1:100-1:300 -
Protocols:
-
儲存條件:Upon receipt, store at -20°C or -80°C. Avoid repeated freeze.
-
貨期:Basically, we can dispatch the products out in 1-3 working days after receiving your orders. Delivery time maybe differs from different purchasing way or location, please kindly consult your local distributors for specific delivery time.
-
用途:For Research Use Only. Not for use in diagnostic or therapeutic procedures.
相關產品
靶點詳情
-
功能:Hydrolyzes 2-acetyl monoalkylglycerol ether, the penultimate precursor of the pathway for de novo synthesis of platelet-activating factor. May be responsible for cholesterol ester hydrolysis in macrophages. Also involved in organ detoxification by hydrolyzing exogenous organophosphorus compounds. May contribute to cancer pathogenesis by promoting tumor cell migration.
-
基因功能參考文獻:
- Authors discovered that the presence of cholesterol, LDLR-mediated cholesterol endocytosis, and cholesterol efflux are all essential to NCEH-1-mediated neuroprotection. In protecting from alpha-synuclein neurotoxicity, NCEH-1 also stimulates cholesterol-derived neurosteroid formation and lowers cellular reactive oxygen species in mitochondria. PMID: 28934392
- Psoriasis inflammation induced microRNA targets NCEH1 in underlying subcutaneous adipose tissue. PMID: 27015452
- Together, the results define the kinetics of inhibition of KIAA1363 by active metabolites of agrochemicals and indicate that KIAA1363 is highly sensitive to inhibition by these compounds. PMID: 26617293
- Pioglitazone increases ABCA1 expression in an LXR-dependent manner and NCEH1 expression in an LXRalpha-independent manner. PMID: 25280398
- Inhibition of AADACL1 activity with a variety of agents blocked platelet aggregation in response to multiple agonists; blocked activation of the small GTPase RAP1 and protein kinase C (PKC). PMID: 23993462
- NCEH1 is expressed in human atheromatous lesions, where it plays a critical role in the hydrolysis of cholesterol ester in human macrophage foam cells, thereby contributing to the initial part of reverse cholesterol transport in human atherosclerosis. PMID: 20947831
- Ritonavir (at 100 mg once daily and 100 mg twice daily significantly down-regulated neutral cholesterol ester hydrolase 1 in 20 healthy individuals. PMID: 20353815
- KIAA1363, an uncharacterized enzyme highly elevated in aggressive cancer cells, serves as a central node in an ether lipid signaling network that bridges platelet-activating factor and lysophosphatidic acid. PMID: 17052604
- The KIAA1363, an uncharacterized enzyme highly elevated in aggressive cancer cells, serves as a central node in an ether lipid signaling network that bridges platelet-activating factor and lysophosphatidic acid. PMID: 17052608
- NCEH is responsible for a major part of nCEH activity in macrophages and may be a potential therapeutic target for the prevention of atherosclerosis. PMID: 18782767
顯示更多
收起更多
-
亞細胞定位:Cell membrane; Single-pass type II membrane protein. Microsome.
-
蛋白家族:'GDXG' lipolytic enzyme family
-
組織特異性:Expressed in monocyte-derived macrophages. Up-regulated in invasive melanoma and breast carcinoma cell lines.
-
數據庫鏈接:
Most popular with customers
-
-
YWHAB Recombinant Monoclonal Antibody
Applications: ELISA, WB, IHC, IF, FC
Species Reactivity: Human, Mouse, Rat
-
Phospho-YAP1 (S127) Recombinant Monoclonal Antibody
Applications: ELISA, WB, IHC
Species Reactivity: Human
-
-
-
-
-